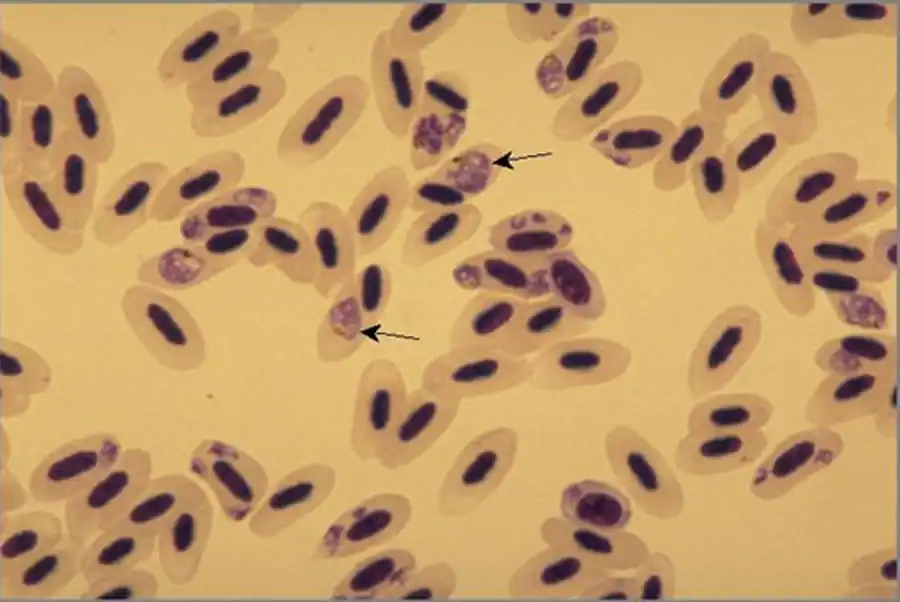

Стадия бесполого размножения Plasmodium
Во время укуса комара, зараженного Plasmodium, серповидные спорозоиты попадают в кровяное русло человека и проникают в клетки эндотелия сосудов печени и других органов.
В тканевых клетках спорозоиты округляются, растут и в результате образуются большие формы — шизонты. Через некоторое время начинается процесс шизогонии: ядро делится, вокруг дочерних ядер обособляются участки протоплазмы и шизонт распадается на столько мерозоитов, сколько образовалось ядер. Тканевые клетки затем распадаются, мерозоиты попадают в ток крови и большая часть их активно проникает в красные кровяные клетки — эритроциты.
У PI. vivax часть мерозоитов вновь проникает в тканевые клетки, и повторяется вышеописанный процесс.
Проникшие в эритроциты мерозоиты, или молодые шизонты, округляются и растут. Через 2—3 ч в них появляется вакуоль, придающая им характерную форму кольца. Вакуоль вскоре исчезает. Через 6 ч в теле ши-зонта появляется бурый пигмент, представляющий собой продукт расщепления гемоглобина, использованного паразитом в процессе ассимиляции.
В это время паразит, представляющий собой взрослую вегетативную форму плазмодия, оживленно амебоидно двигается. Через 36 ч после начала развития в эритроците период роста паразита заканчивается, он округляется, перестает двигаться, начинается деление его ядра на 10—20 частей (обычно 16); дочерние ядра располагаются по периферии шизонта, вокруг каждого из них обособляется участок плазмы, и через 48 ч после проникновения спорозоита в эритроцит наступает множественное деление — шизогония, в результате которой образуются мерозоиты.
Пигмент и часть протоплазмы остаются в виде остаточного тела и погибают. К моменту образования мерозоитов эритроцит разрывается, мерозоиты выходят в кровь, проникают в новые эритроциты, и процесс начинается сначала.
Такое многократное повторение шизогонии приводит к увеличению числа паразитов в крови человека.
Стадии цикла малярийного паразита, размножающиеся в тканевых клетках, называются тканевыми стадиями, или экзоэритроцитарными, развивающиеся в эритроцитах — эндоэритроцитарными.